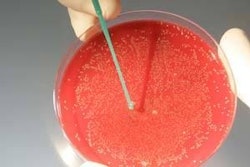
Listeriosis leads to 500 fatalities each year in the USA alone.

A processing site in the UK has recently been recognized for its efforts to protect the environment. Vion Llangefni in North Wales is part of the Vion Food Group and, following changes to the site’s operating procedures carried out in 2006, Vion carried out a “water audit”.
The measures the company implemented in response to this audit led to its work being nominated earlier this year for a Water Efficiency Award.
The Water Efficiency Awards is the leading scheme in England and Wales for recognizing the achievements of organizations that have reduced their environmental impact by becoming more water efficient. Organizer of the scheme, the UK Environment Agency believes that Vion UK serves as an example to other businesses, demonstrating how to reduce cost and environmental impact.
The Llangefni plant operates an eight hour production day, Monday to Friday, and has a workforce of 320 people. The debone side of the factory is completely dry process, meaning that water is only used for cleaning equipment and domestic hygiene.
The bulk of the site’s water is used on primary processing. Most of its machinery is water lubricated, while birds are washed inside and out several times.
To ensure biosecurity, all vehicles that carry birds to the factory are thoroughly washed after each delivery, as is the lairage and yard. In addition, the crates and modules in which the birds are transported from farms are also washed after each delivery.
All processing equipment in the factory, whether in primary or deboning operations is thoroughly cleaned and sanitized after each shift.
In July 2006, the Llangefni plant moved to so a single shift system. This meant a reduction in the number of birds processed, but water consumption did not drop proportionately. This was because, although throughput had been reduced, the physical dimensions of the yard, factory, and all the processing equipment had not.
Scald tanks holding 40m3 of hot water used to soften feathers prior to removal, for example, still held 40 m3 of water, but only half as many birds were using it.
Identification
It was decided to carry out a water audit in conjunction with environmental advisory service Envirowise, and a water minimization program was introduced using the recommendations made in the audit report.
As part of the audit process, data was gathered on how much water was being used at Llangefni, and which parts of the business were using it. Vion says that some of the results were “surprising”, but led to the identification of several areas where the company could focus efforts.
The surprising results were the ones that turned out to be simple to address, leading to “quick wins” at relatively little or no cost.
The use of open-ended hoses for washing down collection vehicles and the intakes yard was a prime example of where a little effort and bit more thought could go a long way.
Change
Vion discovered that a standard hose running open-ended used three times more water than a pressure washer and lance over the same period, but that both approaches gave the same results. Consequently, as many open-ended hoses as possible were withdrawn from the yard and the wash down area resulting in three times less water usage.
Another area that the company had not previously considered was water pressure within the factory. Minor adjustments to water pressure and to equipment yielded savings without detriment to either product or equipment performance.
Water pressure was reduced as a whole and some sprays in the second row of featherators were switched off after being deemed unnecessary. The relocation of the packing room to the source of collection has ensured that large amounts of water are no longer needed to carry product to the cutting room.
Throughout last year, staff at the site concentrated not only on reducing the litres of water per bird as a key performance indicator (KPI), but also the on the total volume of water brought onto the site, allowing two problems to be addressed in one go.
Ongoing effort
Reducing the water brought onto the site yields cost savings and also means less trade effluent to treat and dispose of, which again means lower costs.
The site now carries out regular monitoring of water volumes brought in using PMAC telemetry to read the main water meter and from manual readings of the various submeters the company has installed around the site. Some key pieces of process equipment now have their own meters to monitor specific usage.
But addressing water usage is an ongoing initiative. Water performance is discussed daily at the site management team’s operational meetings and details of monthly performance is posted on site notice boards and on the company intranet.
Over the 12 months following the Envirowise audit and the introduction of the minimization initiatives, the litres per bird has delivered a 19 percent saving. The savings both in water volumes and monetarily have been relatively cheap to achieve.
The work that Vion has carried out has been held up as a “shining example” by the UK’s Environment Agency, yet the company feels that there is still more that it can do, and is further reviewing processes.